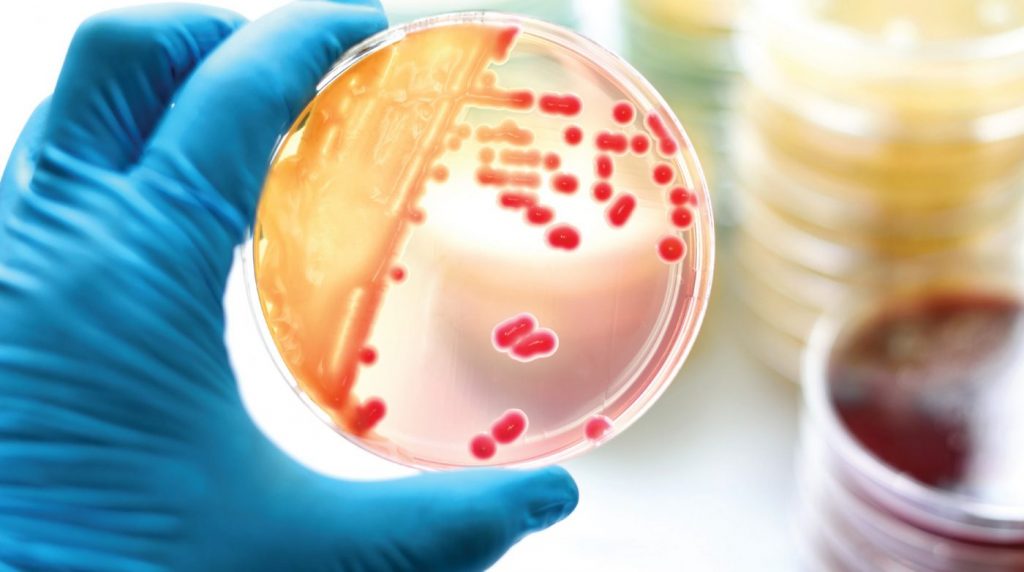

Современной медицине сегодня известно более 30 микроорганизмов, передающихся половым путем, 8 из которых вызывают воспалительные процессы у представителей обоих полов.
Диагностика многих из них стала возможна благодаря появлению новых лабораторных методов.
Обследование на ИППП стоит пройти, если:
- чувствуется дискомфорт, боль и жжение при мочеиспускании, аномальные выделения из уретры;
- ИППП обнаружены у полового партнера;
- был случайный половой акт.

При любых дискомфортных ощущениях в половых органах и в области малого таза необходимо обратиться к врачу и пройти диагностику. Это поможет исключить серьезные последствия. Также совершенно исключено самолечение. В результате таких действий симптомы иногда могут стать менее выраженными, но болезнь не исчезнет. В этом случае вирус переходит в спящую форму, но болезнь так и остается в организме. При подозрениях на ИППП сдать анализы и пройти диагностику необходимо обоим половым партнерам.
Такие заболевания диагностируются исходя из клинических симптомов и результатов лабораторных исследований.
В качестве материала для исследования берется:
- кровь из вены;
- моча (утренняя);
- у женщин берется мазок с внешней части половых органов и соскоб из шейки матки или влагалища;
- у мужчин материал берется урогенитальным зондом из мочеиспускательного канала;
К сдаче анализов необходимо правильно подготовиться чтобы проведенное исследование было информативным и достоверным.
- Кровь необходимо сдавать натощак. Так исследование будет более информативным и достоверным.
- В течение суток перед сдачей анализов нельзя употреблять алкоголь и курить. Желательно ограничить физические нагрузки и постараться избегать стресса.
- Перед взятием соскоба в течение двух дней желательно воздерживаться от половых контактов, а также не мочиться в течение двух-трех часов до процедуры.
- Стоит помнить, что исследование не даст достоверных результатов, если будет проводиться в период лечения антибиотиками.

Также стоит помнить об инкубационном периоде, который есть у любой инфекции. Это период от момента заражения до того, как начнут появляться симптомы заболевания. Инкубационный период при разных ИППП может продолжаться от 5 до 30 дней. В это время анализ может не показать болезнь и анализы придется сдавать повторно.

Своевременная диагностика может сделать лечение более простым и быстрым, в то время как затягивание похода к врачу приводит к осложнениям и может стать причиной необратимых последствий.